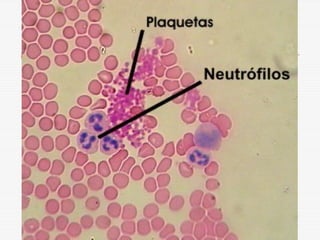
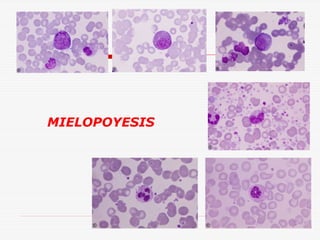
MIELOPOYESIS
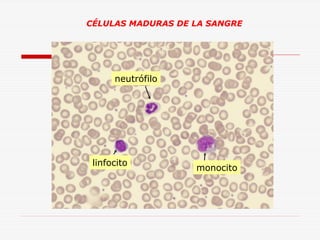
CÉLULAS MADURAS DE LA SANGRE

neutrófilo

linfocito

monocito

Este documento describe la fisiología de la sangre, incluyendo sus funciones principales de transporte, regulación y protección. Explica la composición de la sangre, con énfasis en el plasma, los eritrocitos, la hemoglobina y la eritropoyesis. También cubre la hemostasia y los estudios laboratoriales de la sangre.